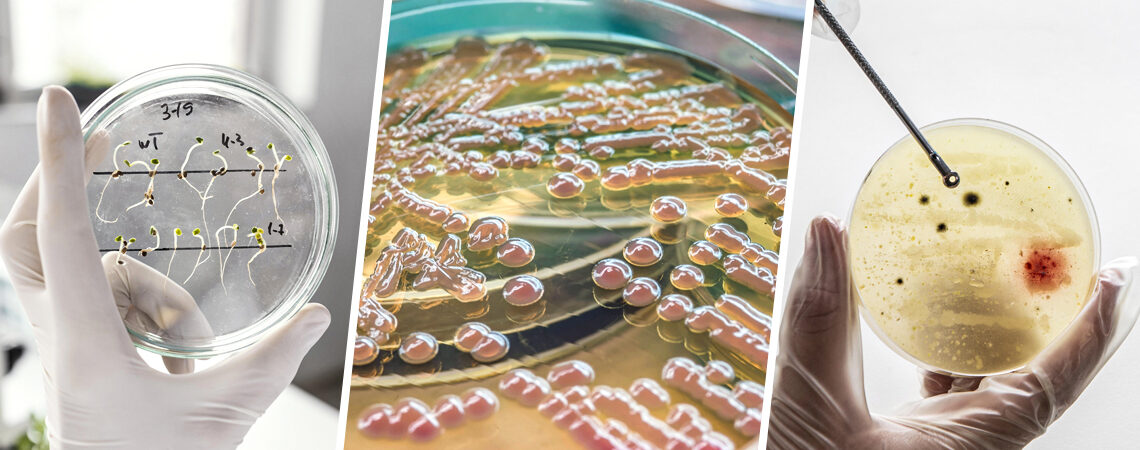

Agarose: Essential Polymer for Scientific Research Agarose is a versatile and widely used polysaccharide primarily derived from the cell walls of certain red algae, such as Gelidium and Gracilaria. It is structurally composed of repeating units of agarobiose, which contains D-galactose and 3,6-anhydro-L-galactose. Agarose forms a gel when dissolved in hot water and subsequently cooled, […]

Recent Comments